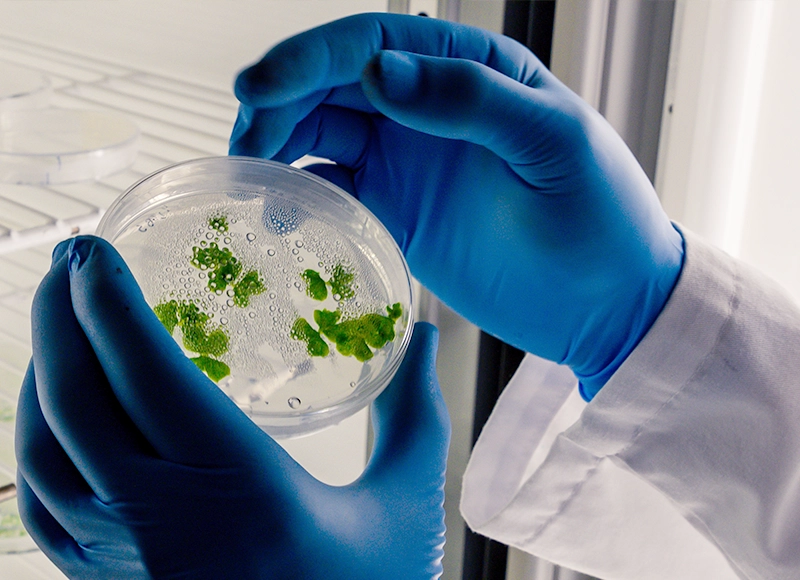

ANA BACTERIANA
Inoculantes bacterianos beneficiosos para plantas, suelos y residuos agropecuarios
Biotecnología novedosa formulada para potenciar la biodiversidad de los suelos, la fotosíntesis vegetal, tratamientos de aguas y gestión de residuos agropecuarios
¿En qué te podemos ayudar?
Nuestros servicios y productos conjugan la ciencia aplicada y de laboratorio
– Servicios –
SERVICIOS AGRÍCOLAS
Consultoría y diseño de soluciones adaptadas a tus necesidades
FUERZA NATURAL PARA TUS CULTIVOS: POTENCIA EL RENDIMIENTO Y CUIDA EL PLANETA CON SOLUCIONES NATURALES
Nuestra oferta de servicios y productos combina procesos complejos de ciencia aplicada y laboratorio. Los inoculantes de Ana Bacteriana, 100% naturales sin modificación genética, son esenciales para el vigor y el rendimiento de las plantas mejorando todos los procesos vegetales.


GESTIÓN DE RESIDUOS AGROPECUARIOS

Consultoría y diseño de soluciones adaptadas a tus necesidades
Transforma residuos en recursos: Soluciones naturales para un campo más limpio y sostenible
Nuestros servicios son la opción ideal para mejorar los procesos de residuos agropecuarios con capacidades incomparables para descomponer residuos y reducir gases tóxicos en granjas ovinas, porcinas, bovinas y avícolas.
¿Qué beneficios generamos?
Resultados que puedes esperar en la biología esencial del suelo y los residuos orgánicos

Mejora de la salud

Resistencia a sequías

Desarrollo radicular

Incrementa la producción

Almacena nutrientes
– Productos –
PARA EL CULTIVO

100% NATURALES, NO TÓXICOS, BIODISPONIBLES Y NO PATOGÉNICOS
Naturaleza en tus manos: Cultiva, cuida y transforma de forma 100% natural y sostenible
Los productos de Ana Bacteriana están compuestos por ingredientes biológicos con formulaciones probióticas no modificadas genéticamente. Estas soluciones sostenibles aseguran una mejora en los procesos vegetales, aumentando el vigor y el rendimiento de plantas, cultivos y suelos.


PARA LA GESTIÓN DE RESIDUOS AGROPECUARIOS

100% NATURALES, NO TÓXICOS, BIODISPONIBLES Y NO PATOGÉNICOS
100% natural: descompone residuos y revitaliza tu granja
Los productos de Ana Bacteriana, elaborados a partir de componentes biológicos que contienen formulaciones probióticas sin alteraciones genéticas, ofrecen soluciones sostenibles para el tratamiento de residuos agropecuarios, destacándose por su eficacia en descomponer desechos y disminuir gases tóxicos en granjas ovinas, porcinas, bovinas y avícolas.
¿En qué te podemos ayudar?
Nuestros servicios y productos conjugan la ciencia aplicada y de laboratorio
Ofrecemos consultoría y diseño de soluciones adaptadas a tus necesidades
CONTACTA CON NOSOTROS
Te informamos sin compromiso de cómo nuestros servicios y productos te pueden ayudar
¿En qué te podemos ayudar?
Nuestros servicios y productos conjugan la ciencia aplicada y de laboratorio
Ofrecemos consultoría y diseño de soluciones adaptadas a tus necesidades
CONTACTA CON NOSOTROS
Te informamos sin compromiso de cómo nuestros servicios y productos te pueden ayudar

Biotecnología 100% natural: potencia tus cultivos y transforma tus residuos orgánicos

